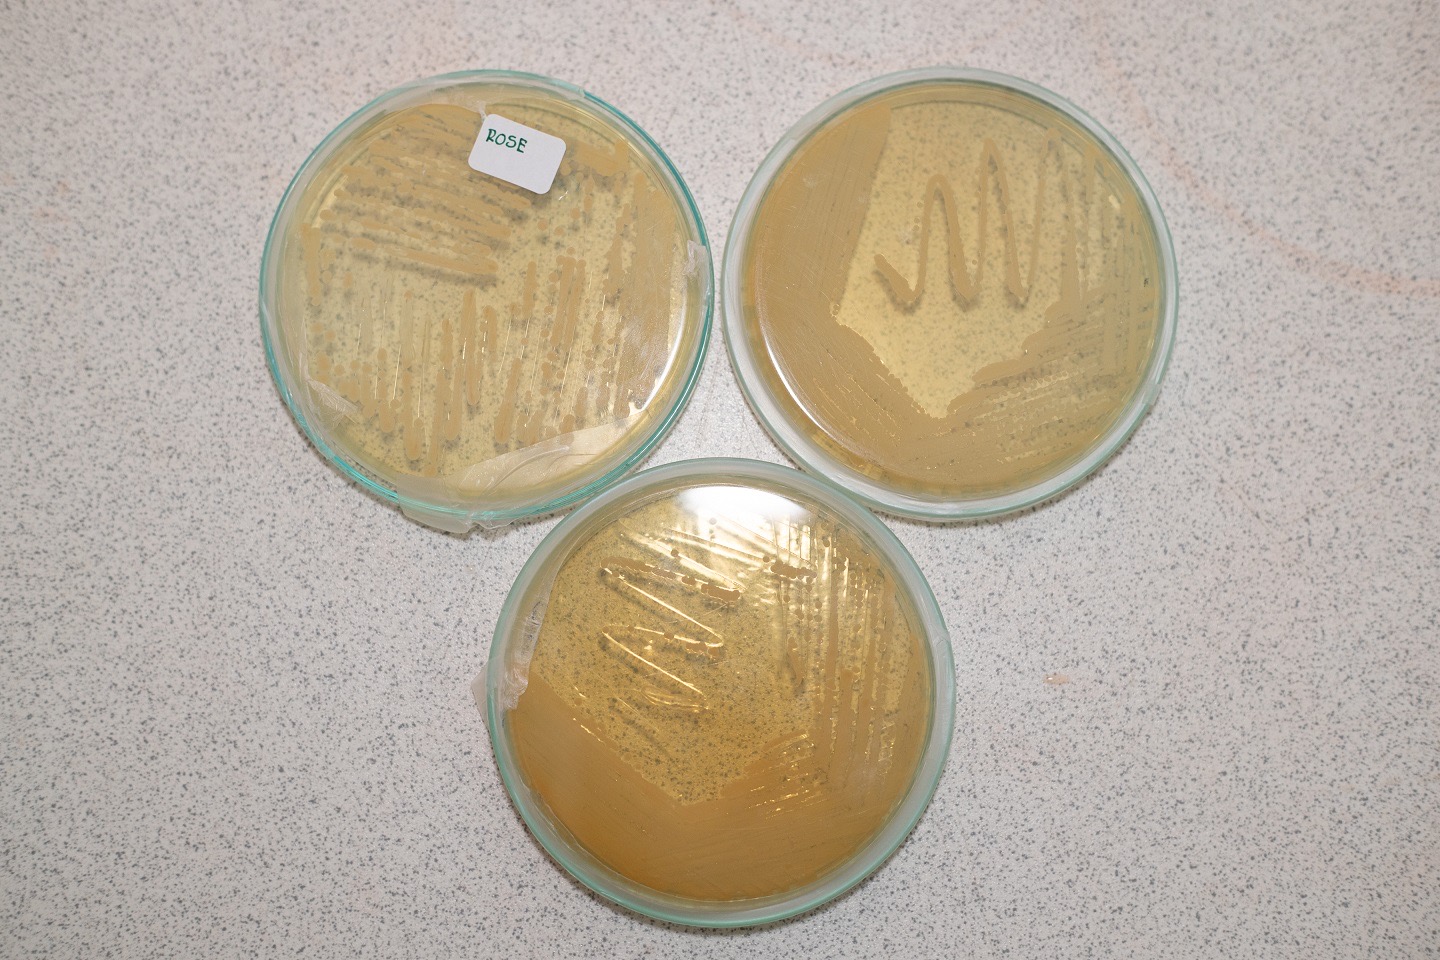
IMAGE - 865

“โปรไบโอติกส์ซุปเปอร์ดริ้ง สปาร์คกลิ้ง ยีสต์คอมบูฉะ” คำตอบของผู้รักษ์สุขภาพ ด้วยกระบวนการหมักแบบธรรมชาติ 100%

คอมบูฉะหรือคอมบูชา (Kombucha) คือเครื่องดื่มชาหมักที่มีจุลินทรีย์ชนิดดี มีประโยชน์ต่อร่างกาย แบคทีเรียและยีสต์บางชนิดที่พบในหมักชาเป็นจุลินทรีย์ในกลุ่มโปรไบโอติกส์ (Probiotics) สามารถช่วยปรับสมดุลในลำไส้ ลดจำนวนแบคทีเรียไม่ดี และทำให้ลำไส้ทำหน้าที่ดูดซึมสารอาหารเข้าสู่ร่างกายได้อย่างมีประสิทธิภาพ นอกจากนี้ในกระบวนการหมักชาเพื่อผลิตคอมบูฉะ น้ำตาลซึ่งเป็นแหล่งอาหารของจุลินทรีย์จะถูกเปลี่ยนด้วยกระบวนการทางชีวภาพเป็นกรดน้ำส้ม (acetic acid) ที่มีกลิ่นหอมอ่อนๆ ชวนดื่ม ชาหมักยังอุดมไปด้วยสารต้านอนุมูลอิสระที่ได้จากใบชาอีกด้วย และนี่คืออีกเหตุผลสำคัญที่ทำให้หลายคนเลือกบริโภคคอมบูฉะ

รศ.ดร.นิษก์นิภา สุนทรกุล อาจารย์ประจำสาขาเทคโนโลยีชีวเคมี คณะทรัพยากรชีวภาพและเทคโนโลยี และหัวหน้าห้องปฏิบัติการวิจัยคุณภาพสูงนวัตกรรมยีสต์ มหาวิทยาลัยเทคโนโลยีพระจอมเกล้าธนบุรี (มจธ.) ให้ข้อมูลว่า ปัจจุบันการบริโภคคอมบูฉะได้รับความนิยมอย่างแพร่หลายทั่วโลก โดยเฉพาะในประเทศโซนอเมริกา แคนาดา ยุโรป ออสเตรเลียและนิวซีแลนด์ และมีแนวโน้มการบริโภคที่เพิ่มขึ้นอย่างต่อเนื่อง คาดการณ์ว่าขนาดตลาดคอมบูฉะทั่วโลกจะมีมูลค่า 13.41 พันล้านดอลลาร์สหรัฐภายในปี 2029 และจะมีอัตราการเติบโตต่อปี (CAGR) ที่ 25% โดยคอมบูฉะที่วางจำหน่ายที่เป็นที่นิยมในต่างประเทศ จะเป็นการหมักชาด้วยสโคบี้ (กลุ่มแบคทีเรียและยีสต์ที่อาศัยอยู่ร่วมกันอย่างสมดุลและสร้างแผ่นใยเซลลูโลสเพื่อเป็นที่อยู่อาศัยและเป็นแหล่งอาหารสำรอง โดยสโคบี้มีลักษณะเป็นแผ่นวุ้นใส รูปร่างคล้ายแพนเค้กหรือเห็ด) โดยที่ผลิตภัณฑ์คอมบูฉะที่ได้รับความนิยมสูงในต่างประเทศ จะเป็นชาหมักที่มีเชื้อจุลินทรีย์ดีที่ยังมีชีวิตอยู่หรือที่เรียกว่า Raw/Craft Kombucha ซึ่งมีราคาสูงแต่ให้คุณค่าทางโปรไบโอติกส์อย่างแท้จริง
“สิ่งที่ผู้บริโภคส่วนใหญ่ไม่ทราบก็คือ ผลิตภัณฑ์คอมบูฉะบรรจุขวดปิดสนิทที่ได้รับการขึ้นทะเบียนในบ้านเรา จะต้องผ่านการฆ่าเชื้อด้วยอุณหภูมิที่สูงมาก แม้จะมีข้อดีคือการกำจัดจุลินทรีย์ที่อาจเป็นโทษต่อร่างกาย ซึ่งอาจจะปนเปื้อนในระหว่างการผลิตที่ไม่สะอาดและไม่ถูกสุขลักษณะ แต่ผู้บริโภคคอมบูฉะแบบนี้อาจจะไม่ได้ประโยชน์หรือคุณค่าทางอาหารอย่างเต็มที่ โดยเฉพาะด้านโปรไบโอติกส์ จุลินทรีย์โดยเฉพาะแบคทีเรียซึ่งเป็นสิ่งมีชีวิตที่ไม่ทนความร้อนสูง ก็จะตายไปหรือเหลือรอดน้อยมาก นอกจากนี้สารฟังก์ชั่น อาทิ สารต้านอนุมูลอิสระก็เหลือค่อนข้างน้อยเนื่องจากถูกทำลายไปกับความร้อน”
จากการทำวิจัยกว่า 16 ปี ณ ห้องปฏิบัติการวิจัยคุณภาพสูงนวัตกรรมยีสต์ มหาวิทยาลัยเทคโนโลยีพระจอมเกล้าธนบุรี ทางทีมวิจัยนำโดย รศ.ดร.นิษก์นิภา หัวหน้าห้องปฏิบัติการนวัตกรรมยีสต์และทีม ได้ศึกษาและพัฒนาคุณสมบัติยีสต์สายพันธุ์ต่างๆ ให้ได้ซุปเปอร์ยีสต์ Super Yeast เพื่อการประยุกต์ใช้ทางอุตสาหกรรมและทางการแพทย์ จึงเป็นที่มาของ “โปรไบโอติกส์ซุปเปอร์ดริ้ง สปาร์คกลิ้ง ยีสต์คอมบูฉะ” ที่ผู้บริโภคมั่นใจว่าจะได้รับคุณค่าความเป็นโปรไบโอติกส์จากยีสต์ดี มีประโยชน์ต่อร่างกายโดยไม่ถูกทำลายไปจากกระบวนการฆ่าเชื้อด้วยความร้อน
“เนื่องจากยีสต์ที่เราใช้ในผลิตภัณฑ์ต้นแบบ จะเป็น Super Yeast กลุ่มยีสต์โปรไบโอติกส์ที่มีความแข็งแกร่งมากๆทนทานสภาวะการหมักได้ดี เราพัฒนาขึ้นโดยใช้เทคโนโลยีชีวภาพจุลินทรีย์ โดยใช้เทคนิคพิเศษด้วยวิธีทางวิวัฒนาการในการปรับปรุงคุณสมบัติให้ยีสต์สามารถทนกรดสูง ผลิตกรดแอซิติกสูงแต่แอลกอฮอล์น้อย ทนต่อความร้อน ทำให้ยีสต์โปรไบโอติกส์สายพันธุ์นี้สามารถมีชีวิตรอดในอุณหภูมิที่สูงได้ คอมบูฉะมีความซ่า บับบลิ้งจากคาร์บอนไดออกไซด์ที่ได้จากการหมักจึงมีความสปาร์กลิ้งแบบเป็นธรรมชาติ ให้ความสดชื่นคล้ายกับไซเดอร์ และในการหมักชาเรายังมีการใช้เติม Super Yeast ยีสต์กลุ่มอะโรมาติกส์ ที่ให้สารออกฤทธิ์ทางชีวภาพ สารต้านอนุมูลอิสระอื่นๆ ที่คุณสมบัติเด่นในการชะลอวัย เช่น สารเคอร์ซีทิน (quercetin) แถมผลิตสารกลุ่ม Fruity Flora ที่ช่วยเพิ่มกลิ่นรสโดยธรรมชาติที่หอมและความละมุน ในปริมาณที่สูงกว่ายีสต์ทั่วไปกว่า 14 เท่า จึงทำให้คอมบูฉะของเรามีรสชาติและกลิ่นรสผลไม้ผสมกลิ่นกุหลาบที่หอม นุ่มนวลเป็นเอกลักษณ์ของยีสต์คอมบูฉะ ที่สามารถทางเลือกใหม่สำหรับผู้บริโภคที่รักสุขภาพ มองหาเครื่องดื่มทดแทนน้ำหวาน น้ำอัดลม หรือไวน์ซึ่งมีราคาสูงกว่ามาก”
รศ.ดร.นิษก์นิภา ให้ข้อมูลเพิ่มเติมว่า ด้วยคุณค่าของโปรไบโอติกส์ยีสต์ที่มีชีวิต และระยะเวลาในการเก็บรักษาผลิตภัณฑ์ที่ค่อนข้างนาน สามารถเก็บไว้ในตู้เย็นนานกว่า 6 เดือนโดยไม่เติมสารกันเสีย จากผลการตอบรับที่ดีจากการทดสอบตลาดที่กลุ่มเป้าหมายชอบที่กลิ่นรสหอมละมุน ทำให้ทานง่ายกว่าคอมบูฉะที่หมักด้วยแลคติกแบคทีเรียเพียงอย่างเดียว (การหมักด้วยแลคติคแอซิดแบคทีเรียจะผลิตกรดแลคติกที่สูง ซึ่งมีกลิ่นฉุนคล้ายกับพลาสติก) จนทำให้คอมบูฉะของเราได้รับความสนใจจากภาคเอกชนหลายราย
“ปัจจุบันมีผู้ประกอบการที่สนใจติดต่อมาเพื่อร่วมกันพัฒนาสูตรยีสต์คอมบูฉะ ให้ตรงกับความต้องการของกลุ่มลูกค้าของบริษัท ทางทีมสามารถนำความเชี่ยวชาญด้านนวัตกรรมยีสต์มาถ่ายทอดกระบวนผลิตชาหมักและเทคโนโลยีชีวภาพที่เกี่ยวข้อง อาทิ การเพิ่มปริมาณสารสำคัญที่พบหลังกระบวนการหมักของจุลินทรีย์ก็เป็นอีกหนึ่งโจทย์ที่น่าสนใจในการเพิ่มคุณค่าให้กับผลิตภัณฑ์ เพราะนอกจากวัตถุดิบกลุ่มชาแล้ว ยังสามารถนำนวัตกรรมยีสต์มาปรับใช้ในกลุ่มวัตถุดิบทางการเกษตรอื่นๆ ได้หลากหลาย เพื่อให้ได้ผลิตภัณฑ์ชนิดใหม่ที่ตรงใจกลุ่มผู้บริโภคทั้งในกลุ่มตลาดพรีเมียมและตลาดแมส”
อนึ่ง ยีสต์โปรไบโอติกส์และยีสต์อะโรมาติกส์ดังกล่าว จัดเป็นของ Super Yeast ที่พัฒนาขึ้นเพื่อใช้ในการผลิตอาหารและเครื่องดื่มฟังก์ชั่น โดยห้องปฏิบัติการวิจัยคุณภาพสูงนวัตกรรมยีสต์ มจธ. หากผู้ประกอบการสนใจนำไปใช้ประโยชน์ในอุตสาหกรรม สามารถติดต่อขอข้อมูลเพิ่มเติมหรือปรึกษาการพัฒนาผลิตภัณฑ์จากยีสต์ ได้ที่ เบอร์โทรศัพท์ 02-470-7767 หรือทาง E-mail: nitnipa.soo@kmutt.ac.th